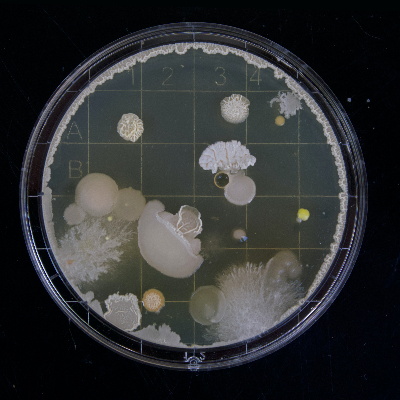

Otto Krummel
Releases
Demos
About Otto Krummel
Otto Krummel is a time traveler. Through his journeys he collects unusual sounds and use them in his production. Mostly it’s a brokenbeat electronica full of different textures from various epochs. Otto shares his music as audio-visual broadcasting from the past with retro video cuts from public archives. The combination of modern electronic music and old b&w videos brings a unique connection between different epochs. Otto Krummel builds his own tribe around this genre and involves new listeners curating his own playlist on Spotify. As a DJ he prefers music like Max Cooper, Alex Banks, Lorn, Bonobo, Daniel Avery, Bicep.
Otto Krummel is a time traveler. Through his journeys he collects unusual sounds and use them in his production. Mostly it’s a brokenbeat electronica full of different textures from various epochs. Otto shares his music as audio-visual broadcasting from the past with retro video cuts from public archives. The combination of modern electronic music and old b&w videos brings a unique connection between different epochs. Otto Krummel builds his own tribe around this genre and involves new listeners curating his own playlist on Spotify. As a DJ he prefers music like Max Cooper, Alex Banks, Lorn, Bonobo, Daniel Avery, Bicep.